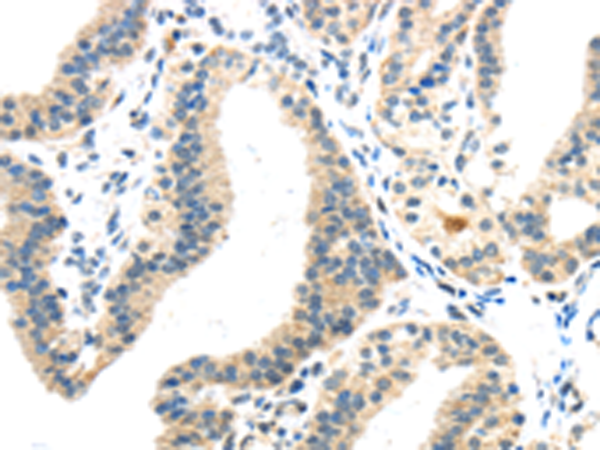

-
分类: 科研抗体货号: P10973别名:应用: WB,IHC反应种属: Human, Mouse
-
分类: 科研抗体货号: P10988别名:应用: IHC反应种属: Human
-
分类: 科研抗体货号: P10978别名: JTK10, THCYT3应用: IHC反应种属: Human, Rat
-
分类: 科研抗体货号: P10972别名:应用: IHC反应种属: Human, Mouse, Rat
-
分类: 科研抗体货号: P10987别名: KV3.4; C1orf30; KSHIIIC; HKSHIIIC应用: WB反应种属: Human, Mouse, Rat
-
分类: 科研抗体货号: P10977别名: IRS-4; PY160应用: IHC反应种属: Human
-
分类: 科研抗体货号: P10971别名:应用: WB,IHC反应种属: Human, Mouse, Rat
-
分类: 科研抗体货号: P10986别名: KV4, NGK2, KV3.1应用: WB,IHC反应种属: Human, Mouse
-
分类: 科研抗体货号: P11005别名: HBM, LR3, OPS, EVR1, EVR4, LRP7, OPPG, BMND1, OPTA1, VBCH2应用: IHC反应种属: Human, Mouse
-
分类: 科研抗体货号: P10985别名: KV3.2应用: IHC反应种属: Human, Mouse, Rat

鄂公网安备42018502007531号
鄂公网安备42018502007531号

